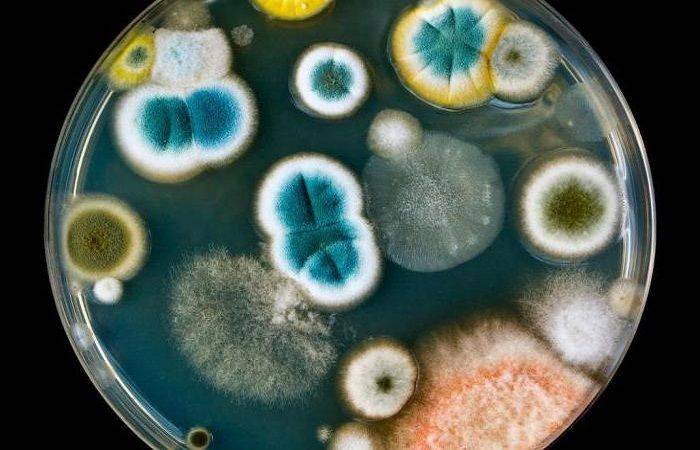

Особенности распространения семени и споры
Семя обладает уникальной структурой и содержит эмбрионную растительную клетку вокруг запасных питательных веществ. Семя довольно крупное и кажется легко заметным. Оно может с легкостью путешествовать на значительные расстояния, при этом оставаясь в состоянии покоя. Семя способно выжить в различных условиях, чтобы развиться в новую растительную особь. Растение порождает семена в результате полового размножения, что позволяет иметь большое разнообразие потомства.
На другом конце спектра находятся споры. Споры — это маленькие одноклеточные структуры, которые образуются путем специальной репродукции растения. Споры обычно невооруженным глазом не видны и не имеют запасных питательных веществ. Они достаточно легкие и могут распространяться с помощью ветра или воды. Споры представляют собой образец бесполого размножения и развиваются в новые особи растений без половой фазы.
- Семена могут быть распространены животными, которые питаются плодами и потом их семенами и выделяют их вместе с пометом на новом месте.
- Семена также могут распространяться с помощью ветра, когда растение порождает пух или крылышки, которые помогают им парить на ветру на значительные расстояния.
- Распространение спор малоизвестно насекомым и животным. Однако они могут легко распространяться с помощью воздушных потоков или переносчиков воды.
- Распространение спорами обеспечивает высокую мобильность и быстрое распространение потомства растений.
Хотя семена и споры имеют различные методы распространения, оба они важны для жизненного цикла растений и помогают им выжить и развиваться в разных условиях.
Изучение различий между семенем и спорой позволяет нам лучше понять разнообразие растений и способы их размножения. Оба этих структуры имеют свои уникальные особенности и применение.
Семена – это форма размножения многих цветковых растений, гименоспермных и некоторых плауних растений. Семена характеризуются наличием эмбриона, окруженного защитной оболочкой, которая обеспечивает его питание и защищает от внешних воздействий. Семена способны выживать в различных условиях, что делает их удобными для передачи генетической информации от одного поколения к другому. Семена используются в сельском хозяйстве, садоводстве и в процессе создания новых сортов и гибридов растений.
Споры – это форма размножения многих низших растений, таких как папоротники, мохи и водоросли. Споры выполняют роль аналогичную семенам, но отличаются своим строением и способом распространения. Они являются генетическим материалом, способным выживать в неблагоприятных условиях и затем прорастать, давая начало новым растениям. Споры используются в лесном хозяйстве, растениеводстве и аквариумистике.
Понимание различий между семенем и спорой позволяет садоводам, фермерам и ученым лучше управлять и разводить растения для получения желаемых результатов. Использование семян и спор для распространения и улучшения растений является важным аспектом сельского хозяйства и науки о растениях.
Интересно отметить, что наличие семян или спор зависит от типа растения. Высшие растения, такие как деревья, цветы и овощи, размножаются семенами, а низшие растения, такие как папоротники и мохи, размножаются спорами.
Размножение с помощью семени и споры
Основное различие между семенем и спорой состоит в способе размножения. Семя и спора — это два разных способа, которыми растения могут создавать новые особи.
Семя — это орган размножения, образующийся при цветении растений. Оно содержит эмбрион, который обладает всей необходимой информацией для развития нового растения. Семя может быть оплодотворенным или бесплодным. Оплодотворенное семя может прорастать и создавать новое растение, в то время как бесплодное семя нет. Семена могут распространяться ветром, животными или через воду.
Спора — это специализированная клетка, которая образуется у некоторых растений, водорослей, грибов и мохов. Она является результатом мейоза и содержит только половые клетки — споры. Споры растений могут быть одноклеточными или многоклеточными. Они могут быть перенесены ветром, водой или животными на новые места, где они прорастают и формируют новые растения.
Сравнительная таблица размножения с помощью семени и споры:
| Семя | Спора |
|---|---|
| Оплодотворенное или бесплодное | Половые клетки |
| Содержит эмбрион | Результат мейоза |
| Распространяется животными, ветром или водой | Распространяется животными, ветром или водой |
В зависимости от вида растения и его способа размножения, семя или спора могут быть предпочтительным способом размножения. Оба способа имеют свои преимущества и недостатки и способствуют разнообразию растительного мира.
Размножение с помощью семени
Основное различие между семенем и спорой состоит в их структуре и способе размножения.
Семя — это структурная единица, содержащая зародыш растения, покрытая оболочкой. Семенное размножение является основным способом размножения сосудистых растений. При семенном размножении растения используют свои половые органы для опыления и формирования семени.
Процесс размножения с помощью семени включает несколько этапов:
- Опыление. Пыльцевые зерна, содержащие мужские половые клетки, попадают на женские половые органы растения.
- Оплодотворение. Половые клетки соединяются, образуя зиготу.
- Формирование семени. Зигота развивается внутри семени, которое затем вырастает из пестика или плодолистика растения.
- Распространение. Семена рассеиваются окружающей средой и могут прорастать, давая новые растения.
Семенное размножение обладает рядом преимуществ. Семена могут выживать в различных условиях, долго сохранять свою жизнеспособность, передавать генетическую информацию от родителей к потомству. Также семена помогают растениям распространяться на большие расстояния.
Семенное размножение широко распространено у высших растений, таких как деревья, травы и цветы. Оно является одним из ключевых механизмов их размножения и позволяет им адаптироваться к различным условиям среды.
Учебный курс по сравнению свойств семян и спор
Учебный курс по сравнению свойств семян и спор предназначен для тех, кто интересуется изучением различий и сходств между этими двумя формами репродукции у растений.
В ходе курса вы научитесь разбираться в основных характеристиках семян и спор, их структуре, жизненном цикле, их роли в размножении и приспособлении к среде обитания.
Вы также узнаете, какие процессы происходят в семенах и спорах, когда они прорастают и становятся новыми растениями. Вы сможете сравнить разные виды семян и спор, их размеры, формы, цвета и структуру.
Курс включает в себя лекции, практические занятия и лабораторные работы, позволяющие получить практические навыки в работе с семенами и спорами. Вы ознакомитесь с методиками сбора, хранения и выращивания семян и спор, а также с различными методами диагностики и исследования их свойств.
По окончании курса вы получите сертификат, подтверждающий вашу компетенцию в области сравнительного изучения свойств семян и спор.
В чем отличие
Рассматриваемые элементы культур имеют много отличий. Они затрагивают структуру, химический состав и другие особенности.
Строение
Основным отличием семени от споры считается наличие зародыша, который представляет собой прообраз будущего растения. К его составляющим относятся стебелек, корешок и почечка. Для развития будущей культуры зародыш окружает запас питательных элементов, который называют эндоспермом. Дополнительно его защищает семенная кожура. Для спор наличие зародыша не характерно. Они отличаются более простым строением и считаются полифункциональными.
Химический состав
Споры практически не содержат питательных элементов. При этом семена включают белки, жиры, крахмал, немного воды. Наличие этих компонентов повышает жизнеспособность.
Прорастание
Клетки спор могут прорасти лишь в конкретных условиях. При нехватке тепла, света и влаги они гибнут. Семена содержат много питательных элементов, потому они могут переждать влияние неблагоприятных факторов. С наступлением подходящего периода они дадут жизнь новому организму.

Распространение
Семена могут распространяться такими способами:
- Саморазбрасывание. Семечки множества культур падают около материнского растения после вскрытия плодов. Большие семена, как правило, осыпаются под влиянием силы тяжести. У многих культур семечки осыпаются при раскачивании веток или плодоножек.
- Распространение ветром. Посевной материал множества растений распространяется при помощи ветра. Обычно это касается мелких зерен или семечек с волосками.
- Распространение водой. Этот способ применяют не только водные, но и ряд наземных культур.
- Распространение с помощью животных. Чаще всего животные распространяют семена на теле вместе с плодами.
Роль
В современном мире семенные культуры считаются вершиной эволюционного процесса. Спорами размножаются лишь водоросли, хвощевидные, плауновидные растения. Также этот метод используют папоротникообразные культуры. Все остальные культуры на планете считаются семенными.
Влияние на разнообразие растений
Разнообразие растительного мира на планете в значительной мере определяется различными способами размножения растений. Способ размножения влияет на уровень генетического разнообразия в популяциях растений и обеспечивает возможность адаптации к различным условиям среды.
Один из способов размножения растений — семенное размножение. Семена обладают большой преимущественной перспективой для выживания и распространения. У семенных растений есть возможность образовывать прочные покровы, благодаря чему они могут долго сохранять свою жизнеспособность в неблагоприятных условиях. Кроме того, семена могут быть выносимы на большие расстояния различными носителями, такими как ветер, вода или животные. Это позволяет распространиться на новые территории и создать новые популяции растений.
Другой способ размножения — споровое размножение. Споры служат для распространения растений, которые не образуют семян. Они позволяют растениям размножаться без участия половых клеток. Споры обычно легкие и могут быть перенесены ветром на значительные расстояния. Растения, размножающиеся спорами, встречаются в различных экосистемах, включая лесные, водные и пустынные.
Влияние на разнообразие растений в экосистемах
Разнообразие способов размножения растений имеет значительное влияние на биологическое разнообразие в экосистемах. Внезапные изменения условий среды, такие как климатические изменения или вредные воздействия насекомых или болезней, могут привести к значительному снижению численности популяции растений. Однако благодаря разнообразию способов размножения растения имеют широкий спектр стратегий для адаптации и выживания.
Например, растения, размножающиеся спорами, могут быстро колонизировать новые территории, так как споры могут легко распространяться на большие расстояния. Это позволяет им заполнять свободные экологические ниши и создавать условия для возникновения новых популяций растений.
Значение для устойчивости экосистем
Разнообразие способов размножения растений также играет важную роль в устойчивости экосистем. В случае, если один способ размножения становится уязвимым для вредных воздействий или изменений среды, другой способ может обеспечить выживаемость популяции растений. Например, если растения, размножающиеся семенами, становятся уязвимыми для засухи, растения, размножающиеся спорами, могут сохранить разнообразие видов и предотвратить полное исчезновение растительного покрова.
| Способы размножения растений | Примеры растений |
|---|---|
| Семенное размножение | Деревья, кустарники, цветы |
| Споровое размножение | Папоротники, мхи, водоросли |
Таким образом, способы размножения растений имеют огромное значение для разнообразия растительного мира и наличия устойчивых экосистем. Их комбинация позволяет растениям адаптироваться к различным условиям среды, распространяться на новые территории и сохранять разнообразие видов.
чем спора отличается от семени?
Спора — одноклеточная единица расселения, имеет малый запас питательных веществ. Спора прорастает при поступлении в клетку влаги. Низшие и многие высшие растения размножаются спорами, не имеющие многоклеточных покровов (исключение Харовые водоросли) .
Семя — орган полового размножения и расселения семенных растений, обычно развивающийся из оплодотворенного семязачатка. Семя — многоклеточная структура, объединяющая запасающую ткань, зародыш и защитный покров.
1. Семя — многоклеточное, спора — одноклеточная 2. В споре нет запаса питательных веществ и зародыша, а в семени есть и то, и другое. 3. Семя покрыто семенной кожурой, а спора всего-навсего оболочкой.
Таким образом будущее поколение растений в семени защищено лучше, поэтому семенные растения преобладают над споровыми по видовому разнообразию.
Споры растений — микроскопические зачатки низших и высших растений, имеющие разное происхождение и служащие для их размножения и (или) сохранения при неблагоприятных условиях. Представляют собой одноклеточные, реже двуклеточные или состоящие из нескольких клеток образования. Обычно более или менее шарообразной, эллипсоидальной формы, реже — цилиндрической и др. Спородерма
Совокупность оболочек споры, спородерма (от sporá + dérma — «кожа, оболочка») , имеет сложное строение, дифференцируясь на наружный толстый слой, экзину (англ. exine), и внутренний — интину. Экзина состоит из спорополленина, одного из самых стойких органических веществ, способного выдерживать длительные температурные и химические воздействия . Благодаря стойкости экзины, споры обычно длительное время сохраняют способность к прорастанию и могут сохранятся в отложениях на протяжении геологических эпох. Спородерма часто имеет скульптурированные оболочки, покрытые гребешками, бугорками, шипами и т. д.
Спора — одноклеточная единица расселения, имеет малый запас питательных веществ. Спора прорастает при поступлении в клетку влаги. Низшие и многие высшие растения размножаются спорами, не имеющие многоклеточных покровов (исключение Харовые водоросли) .
Семя — орган полового размножения и расселения семенных растений, обычно развивающийся из оплодотворенного семязачатка.
Семя — многоклеточная структура, объединяющая запасающую ткань, зародыш и защитный покров.
1. Семя — многоклеточное, спора — одноклеточная 2. В споре нет запаса питательных веществ и зародыша, а в семени есть и то, и другое. 3. Семя покрыто семенной кожурой, а спора всего-навсего оболочкой.
Таким образом будущее поколение растений в семени защищено лучше, поэтому семенные растения преобладают над споровыми по видовому разнообразию.
Споры растений — микроскопические зачатки низших и высших растений, имеющие разное происхождение и служащие для их размножения и (или) сохранения при неблагоприятных условиях. Представляют собой одноклеточные, реже двуклеточные или состоящие из нескольких клеток образования. Обычно более или менее шарообразной, эллипсоидальной формы, реже — цилиндрической и др. Спородерма
Совокупность оболочек споры, спородерма (от sporá + dérma — «кожа, оболочка») , имеет сложное строение, дифференцируясь на наружный толстый слой, экзину (англ. exine), и внутренний — интину. Экзина состоит из спорополленина, одного из самых стойких органических веществ, способного выдерживать длительные температурные и химические воздействия . Благодаря стойкости экзины, споры обычно длительное время сохраняют способность к прорастанию и могут сохранятся в отложениях на протяжении геологических эпох. Спородерма часто имеет скульптурированные оболочки, покрытые гребешками, бугорками, шипами и т. д.
Ести кратко то так: В споре нет запаса питательных веществ и зародыша, а в семени есть и то, и другое. ..Семя покрыто семенной кожурой, а спора всего-навсего оболочкой. Таким образом будущее поколение растений в семени защищено лучше, поэтому семенные растения преобладают над споровыми по видовому разнообразию.
Значит. спора- это одноклеточные организмы. семя это орган размножения растений.
Жизненный цикл
Жизненный цикл растений включает несколько стадий, начиная с зарождения нового организма и заканчивая его смертью или возобновлением через процесс размножения. Жизненный цикл семенных растений, таких как цветы и деревья, имеет свои особенности.
1. Зародыш. Жизненный цикл начинается с появления зародыша – молодого организма, который образуется из оплодотворенного яйца или семени. Зародыш содержит все необходимые клетки и органы, чтобы вырасти в полноценное растение.
2. Рост и развитие. После появления зародыша начинается активный рост и развитие растения. Зародыш прорастает и выходит над землей в виде проростка, который постепенно становится зрелым растением.
3. Цветение. В процессе цветения растение образует цветки, в которых происходит опыление – перенос пыльцы с тычинки на пестики. Опыление может быть автогамным (самоопыление) или аллогамным (аллельное опыление).
4. Плодоношение. После опыления происходит образование плода, в котором образуются семена. Плод предназначен для защиты и размещения семян, а также для их распространения при помощи различных механизмов – ветра, животных или воды.
5. Размножение. Семена выполняют функцию размножения растений. Когда семена попадают в благоприятные условия (например, достаточное количество влаги и тепла), они прорастают и образуют новые растения. Этот процесс называется герминацией.
6. Смерть или возобновление. После периода роста и размножения растение может умирать или начать жизненный цикл заново, через процесс размножения. Некоторые растения могут жить только один сезон, другие – много лет или даже столетия.
Мельчайшие клетки, к которым способны привести болезни
Микроскопические организмы, такие как бактерии, вирусы и грибы, скрывают в себе потенциал вызвать различные болезни у человека и животных. Бактерии способны размножаться и выживать в разных условиях, в том числе внутри нашего организма, что может привести к инфекционным заболеваниям.
Вирусы, в свою очередь, не являются полноценными клетками, но имеют генетический материал и способность к размножению. Они заражают клетки организма, превращая их в свои «фабрики» для производства новых вирусных частиц. Болезни, вызванные вирусами, могут быть очень разнообразными — от простуды и гриппа до серьезных вирусных инфекций.
Грибы также являются микроскопическими организмами, которые могут вызывать заболевания. Они могут поражать кожу, ногти, волосы и слизистые оболочки, вызывая грибковые инфекции. Грибы также могут атаковать внутренние органы и системы организма.
Болезни, вызываемые этими микроорганизмами, могут иметь различные симптомы и тяжесть. Некоторые болезни могут быть легкими и пройти самостоятельно, в то время как другие требуют медицинского вмешательства и лечения. Уровень заразности и способность распространения микроорганизмов также различается.
В целом, эти микроорганизмы могут быть причиной различных болезней, от обычной простуды до серьезных инфекций. Поддержание гигиены, прививки и правильное лечение могут помочь предотвратить распространение инфекционных заболеваний и защитить наше здоровье.
Функции семени и споры
Основные различия между семенами и спорами
- Семена – это созревшие семязачатки цветкового растения. Напротив, споры — это репродуктивные клетки, ответственные за развитие нового растения или организма без слияния споры с другой репродуктивной клеткой.
- Семена большие и макроскопические, а споры очень маленькие и микроскопические.
- Семенам для прорастания требуется меньше воды, а спорам — больше.
- Семена могут выжить в очень суровых условиях, в то время как споры менее способны, чем семена, и менее склонны к выживанию в суровых условиях.
- Семена содержат эндоспермы, которые хранят питательные вещества для роста зародыша. Споры, с другой стороны, не содержат зарезервированной пищи.
- Животные рассеивают семена, а споры в основном разносятся ветром и водой.
- Семена многоклеточные, а споры одноклеточные.
- Семена являются единицами полового размножения, а споры — единицами бесполого размножения.
- Семена развиваются в процессе митоза из семязачатков с другими оплодотворенными яйцеклетками, тогда как в процессе мейоза спорофита развиваются споры.
- Семена производятся в меньшем количестве, в то время как споры производятся растением в больших количествах.
- Цветковые растения производят семена, а нецветущие растения и грибы — споры.
- Вы можете найти семена внутри плода растения, как в случае с манго. Споры можно найти на нижней стороне листьев папоротника или во мхах и жабрах грибов.
Рекомендации
- https://books.google.com/books?hl=en&lr=&id=I0riES3HoE0C&oi=fnd&pg=PA1&dq=seeds+and+spores&ots=RRt_B_uvhT&sig=7EHnWmTcqEayFddKJLC_hGeL220
- https://www.jstor.org/stable/42765299
Отличительные особенности размножения голосеменных и покрытосеменных растений
Применение
Как семена, так и споры имеют широкий спектр применений в разных областях жизни нашей планеты.
Семена:
| Область применения | Описание |
|---|---|
| Сельское хозяйство | Семена являются основным источником растительного материала для посева и выращивания сельскохозяйственных культур. |
| Ландшафтный дизайн | Семена используются для создания и озеленения парков, садов и других ландшафтных пространств. |
| Фармацевтика и косметология | Семена некоторых растений содержат ценные биологически активные вещества, которые используются в производстве лекарств и косметических средств. |
Споры:
| Область применения | Описание |
|---|---|
| Биологическое исследование | Споры являются важным объектом изучения для биологов, микробиологов и других специалистов, изучающих различные виды организмов и их репродуктивные механизмы. |
| Производство пищевых продуктов | Некоторые виды грибов распространяются спорами и используются в производстве сыра, хлеба, пива и других пищевых продуктов. |
| Медицина | Споры некоторых грибов используются для диагностики различных инфекционных заболеваний. |
Таким образом, и семена, и споры играют важную роль в различных сферах нашей жизни и имеют большое значение для экосистем и человечества в целом.
Различия в происхождении
Основное различие между семенем и спорой состоит в их происхождении и способе размножения.
Семя — это зрелый орган растения, который обладает запасными питательными веществами и способен к прорастанию и развитию новых растений. Семена производятся факультативными растениями (растениями, которые размножаются путем семени и спорами), такими как высшие растения (деревья, цветы, травы).
Спора — это независимая, одноклеточная структура, которая образуется у низших растений и некоторых грибов. Споры создаются в спорангиях или гаметангиях и предназначены для распространения и размножения. Споры меньше и имеют более простую структуру по сравнению с семенем.
Также, семя образуется путем оплодотворения женской репродуктивной клетки (яйцеклетки) мужской репродуктивной клеткой (пыльцой) и развивается внутри завязи. Спора, с другой стороны, образуется путем деления клеток в спорангии и может развиваться независимо от родительского организма, как в случае с мохами и папоротниками.
Таблица ниже суммирует основные различия между семенем и спорой:
Сравнение семени и споры
Семя
Спора
Зрелый орган растения
Независимая структура
Разрастается новый организм
Развивается непосредственно в новый организм
Формируется путем оплодотворения
Образуется путем деления клеток
У высших растений
У низших растений и некоторых грибов
Таким образом, различия в происхождении семени и споры делают их уникальными в своих функциях и способе размножения в растительном мире.
Происхождение семени
Основное различие между семенем и спорой состоит в том, что семя является развитым органом растения, способным к прорастанию и образованию нового растения, в то время как спора — это простейшая форма размножения, позволяющая растению размножаться без полового соединения.
Происхождение семени связано с эволюцией высших растений. У мхов и папоротников размножение осуществляется с помощью спор. Однако у них уже присутствуют некоторые элементы, которые могут рассматриваться как предшественники семени.
Семена появились на Земле примерно 360 миллионов лет назад. Благодаря семенам растения получили возможность колонизировать более широкий спектр сред, чем до этого, и стали более устойчивыми к переменным условиям окружающей среды.
Процесс образования семени называется семяобразованием. Он происходит в результате оплодотворения. После опыления пыльцевой зерно вырастает, образуя пыльцевой порошок и растущую половую трубку, которая проникает в оосферу маточной оболочки и сливается с ней. В результате этого процесса образуется зародыш, который затем развивается в эмбрион растения.
Семя состоит из эмбриона и запасных питательных веществ, таких как нитраты, протеины, углеводы, жиры. Вокруг эмбриона образуется семенная оболочка или семенная иша. Она защищает эмбрион от внешних воздействий, таких как пересыхание, предохраняет его от повреждений и обеспечивает его питание в первое время.
Позвоночные и семенные растения образуют наиболее развитую систему размножения, благодаря которой они успешно заселяют нашу планету и обеспечивают многообразие жизни на Земле.
Происхождение споры
Спора является одним из основных разновидностей вегетативного размножения у растений. В отличие от семени, спора образуется непосредственно на растении и служит для его размножения и распространения.
Семя – это орган репродукции у покрытосеменных растений, который образуется в результате оплодотворения и содержит эмбрион растения, окруженный питательными веществами и защитными оболочками.
Основное различие между спорой и семенем состоит в следующем:
- Происхождение: спора образуется непосредственно на растении, в то время как семя образуется после оплодотворения цветка.
- Структура: спора представляет собой маленькую клетку, обладающую способностью к возрождению в новое растение, в то время как семя содержит эмбрион растения и запас питательных веществ.
- Способ распространения: споры обычно распространяются воздушными или водными потоками, а также с помощью животных, в то время как семена могут быть распространены ветром, животными или людьми.
- Цель: спора служит для размножения и распространения растения, в то время как семя предназначено для обеспечения нового поколения растений.
Таким образом, основное различие между спорой и семенем заключается в их происхождении, структуре, способе распространения и цели.
Разница между спорой и семенем
Как спора, так и семя, являются основной репродуктивной структурой растений, грибов, некоторых бактерий и простейших одноклеточных организмов. Изучение процесса образования позволит более детально изучить жизненный цикл полезных человеку организмов или влиять на распространение опасных для народного хозяйства представителей биосферы.
Термин «споры» относится к репродуктивной структуре низших, высших растений, грибов и споровиков. К тому же, спорами называют плотные оболочки бактерий, которыми они покрываются, чтобы переждать неблагоприятные климатические условия. Такая оболочка способна выдержать экстремальные температуры, механическое давление и влияние агрессивных химических веществ. Кого-то из этих существ «не берет» трехчасовое кипячение, кто-то из них живет исключительно в водоемах с повышенной соленостью или кислотностью.
С помощью таких спорооболочек может проходить расселение организмов, потому что из-за частичного обезвоживания облегченная клетка легко переносится на значительные расстояния. Споры-оболочки не являются органеллами, предназначенными для размножения.
Споры, которые формируются у низших, высших растений и грибов, могут быть одноклеточными и многоклеточными. Они служат для размножения или для пережидания неблагоприятных условий. Верхнюю оболочку споры именуют спородермой из-за особого утолщенного слоя спорополленина, который является одним из самых протестных к химическим и температурным воздействиям веществ. Такая оболочка, укрывшая живой организм, способна сохранить жизнеспособность организма много тысяч лет.

Спора, как репродуктивная структура, появилась у водорослей и встречается у некоторых покрытосеменных, а именно у тех, у которых наблюдается чередование стадии спорофита и гаметофита. При этом, размножение спорофитом – бесполое, хотя без него невозможна стадия половой репродукции. К примеру, цветок высших растений является спорофитом, который образует споры, которые позже трансформируются в гаметофиты. У грибов такие структуры могут образовываться на выростах мицелия или эндогенно, в специальных споро-камерах.
Семя – это производное высших растений, которое служит для размножения и максимального распространения вида. Оно формируется из семязачатка, в результате процесса оплодотворения. Именно в нем находится зародыш будущего растения. Семя — это структура многоклеточная. Его строение является одним из отличительных признаков голосеменных и покрытосеменных растений.
Семена голосеменных включают зародыш растения, обслуживающий его эндосперм и защитную семенную кожуру. Развиваются данные структуры на верхней плоскости семенной чешуи. Семена гинко, тиса, саговника, сосны охотно поедают разные виды птиц и животных.
Семена покрытосеменных растений состоят из плотной, защищающей внутреннее содержимое, семенной кожуры, эндосперма с разным набором хромосом, заполненного крахмалом и жирами перисперма и зародыша. В зародыше, как в эмбрионе животных, четко проглядываются будущие составляющие растения – корешок, стебелек, почечка и семядоли. Только будущие орихидеи не демонстрируют четкой дифференциации на органы до точки проростания.

Так же как и споры, семена защищены семенной кожурой. Они могут достаточно длительное время сохранять жизнеспособность. Известны случаи, когда из лотоса и люпина арктического были пророщены полноценные растения после двенадцатитысячелетнего «анабиоза» семени.
Что такое семя?
Созревшая семяпочка с небольшим зародышевым растением, покрытым оболочкой, называемой семенной оболочкой, называется семенем. Можно также сказать, что это семяпочка, которая находится внутри завязи, которая после оплодотворения превращается в семя. Семя состоит из трех частей: зародыша, эндосперма и кожуры. Некоторые семена могут иметь или не иметь эндосперм.
Единственный источник пищи для роста эмбриона – эндосперм. Функция семенной оболочки – обеспечивать и защищать зародыш, пока он не вырастет в новое растение. Эта семенная оболочка имеет один или несколько защитных слоев для защиты растения от любых повреждений.
Размножение споровых растений
Споровые растения — растения, для которых характерно споровое размножение.
Споровые растительные организмы бывают:
- Низшие: водоросли;
- Высшие: мхи, плауны, хвощи, папоротники.
Размножение водорослей.
- Вегетативное: водоросли размножаются таким способом, когда их части случайно отделяются от материнского организма из-за сильных течений или воздействия животных;
- Споровое: споры водорослей бывают подвижные с жгутиками (зооспоры) и неподвижные; внутри материнской клетки формируется множество спор, которые далее выходят наружу в водную среду;
- Половое: половая репродукция активизируется лишь при наступлении неблагоприятных условий для приспособления к изменяющимся внешним условиям; гаметы из гаметофита сближаются в водной среде и формируют зиготу, из которой формируется новое растение.
Размножение водорослей
Размножение мхов. У мхов выражено чередование поколений. Доминирующим является поколение гаметофит. У кукушкина льна во влажную погоду сперматозоиды из мужского мха перемещаются к яйцеклетке на женском мхе. Бывшая зигота становится спорофитом — коробочкой на ножке. Там формируются споры, которые затем выбрасываются на землю. Из них вырастают мужские и женские мхи — гаметофиты.
Жизненный цикл мха
Размножение плаунов. В жизненном цикле плаунов уже заметно доминирование спорофита над гаметофитом. На зелёном организме — спорофите — образуются спорангии с множеством спор внутри. Споры формируют гаметофит растений, который у плаунов называется заростком. Там формируются мужские и женские половые части, которые производят гаметы. Они сливаются во влажную погоду, образуя спорофит.
Жизненный цикл плаунов
Размножение хвощей. Далее во всех растениях спорофит будет доминирующим поколением. Репродукция хвощей повторяет размножение плаунов. На спорофите образуются споры, из которых вырастает заросток — гаметофит — с женскими и мужскими гаметами.
Жизненный цикл хвощей
Размножение папоротников. Доминирующим поколением папоротников также является спорофит. Спорофит — растение с листьями, на нижней стороне которых образуются бурые бугорки — спорангии. Споры формируют гаметофит — заросток. На нём формируются мужские и женские клетки. При оплодотворении они создают зиготу, из которой развивается спорофит.
Таким образом, репродукция низших и высших споровых растений отличается. Для низших споровых растительных организмов характерен выбор между бесполым или половым размножением. Редко встречается и тот, и другой вид репродукции. Для высших споровых растений характерна смена поколений с преобладанием гаметофита (мхи) или с преобладанием спорофита (плауны, хвощи, папоротники).
































